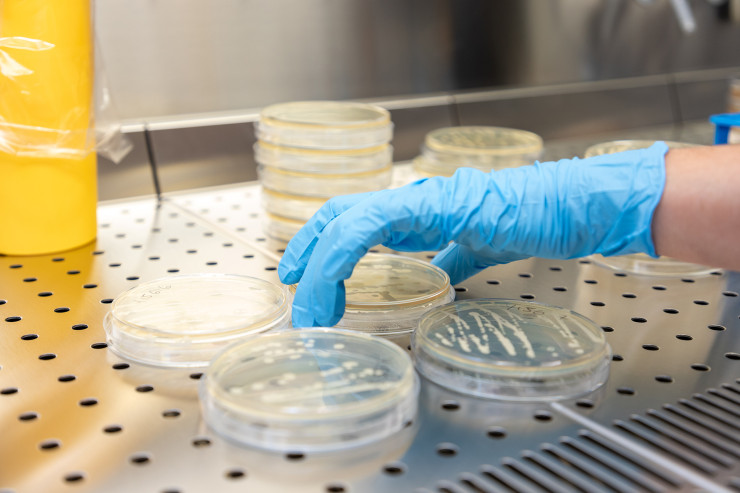

Laboratory for Molecular and Environmental Microbiology
Description
All research groups use this laboratory to carry out research on molecular microbiology. It is divided into two parts: the first one is dedicated to DNA handling and PCR making; the second for gel electrophoresis and band detection and/or cutting
Image + Text
Research Focus
Molecular microbiology
Main Instrumentation
The lab contains a laminar flow cabinet dedicated to PCR and molecular DNA/RNA processing. Dedicated refrigerators for microbiology and DNA/RNA storage; PCR thermal cyclers, microcentrifuges, a Qiagen Real Time PCR, D-Code DGGE gel electrophoresis, machinery for agarose and acrylamide gel electrophoresis, a UV gel electrophoresis detection system (UV-Tec Technologies).
Location
Room E0.23
Head